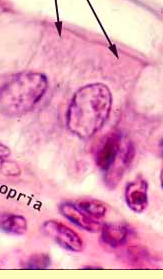

What epidymus layer is this?

What cell layer is A? What does its presence indicate?

What is this cell layer?

Stratum spinosum
What shape are squamous cells?
Squamous means latin for scale, so they are thing scale likes structures
What are the shapes of straitifed squamous cells?
More flat at athe top and more cuboidal at the basal membrane
What is the classification of this epidermous?

Stratified squamous
What is the classification of this epidermous?

Stratified squamous
What classifiation of epidermis is typcially involved with secretion/transport of substances across a single cell layer?
Usually simple columnar cells, but simple cells are good for this as well
What is the classification of this epidermous?

Simple columnar

Practical slides that are simple columnar epithelium
Ileum

Blood vessel
What cell layer?

Stratum basale

Goblet cells
basal bodies below cilia

Transitionally epithelium, a type of pseudostratifed epithelium found in the bladder, ureter, portion of the urethra
Dome cells that are multinucleated and have thick membrane

fixed macrophage
this is a loose connective tissue slide

blue: mast cell
red: collagen
Identify

Loose connective tissue
pink skeletal muscle surround by connective tissue
mast cells: oval cells near bloodv essels, pink puple in color
fixed macrophages: have a lot of blue dots, weirdly shapped
collagen: swiggly pink-orangish lines
fibroblasts: dark purple enlongate ncueli

In stomach
plasma cells
have clock face distrubtion due to their heterochromatin distribution around their eccentric nuclei
bluish cytoplasm with clear golgi

in the stomach…
ovoid euchromatic nuclei

blue - collagen in dermis palpilla
green - collage in reticular layer
red - stratum corneum
What layer is indicated by the blue?
What does it serve as an example of?
What is the papillary layer an example of?

retricular layer
dense irregular connective tissue
loose connective tissue
identify all the structure
what makes the brownish color in the stratum basale?

red - stratum basale
blue - stratum spongiosum
black - stratum granulosum
green- stratum corneum
brownish color is keratinotinocytes